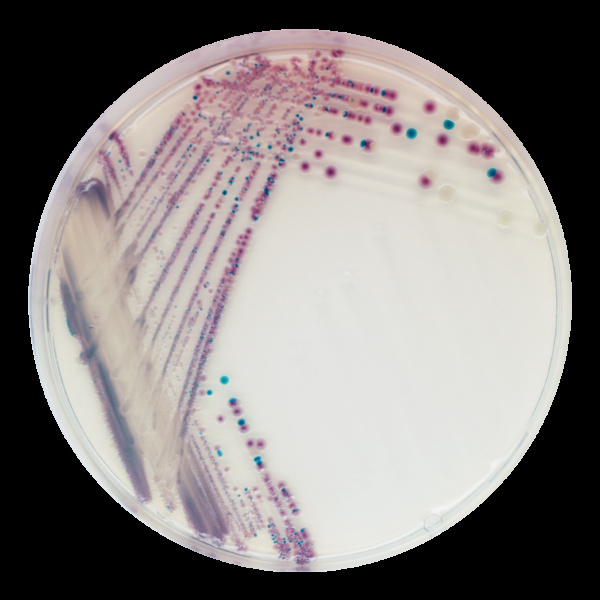
Shop

CHROMagar™ Vibrio
(Chưa có đánh giá)
|
Mã SP: FES-000-4261
CHROMagar™ Vibrio
Mã SP: FES-000-4261
Quét mã QR để xem sản phẩm trên Farmext eShop

SẢN PHẨM
ĐANG CHỜ BÁN LẠI
ĐANG CHỜ BÁN LẠI
Đặc điểm nổi bật
Tên bệnh:
Hoại tử gan tụy cấp tính
- Giai đoạn tôm/thủy sản: Giai đoạn 15-40 ngày sau khi thả nuôi
- Tác hại: Chết hàng loạt
Phát sáng
- Giai đoạn tôm/thủy sản: Ấu trùng, giống
- Tác hại:Chết hàng loạt
Đỏ dọc thân
- Giai đoạn tôm/thủy sản: Ấu trùng, giống
- Tác hại:Chết rải rác
Đỏ thân
- Giai đoạn tôm/thủy sản: Tôm thịt
- Tác hại: Chết rải rác
Bệnh vỏ hay ăn mòn kitin, đen mang
- Giai đoạn tôm/thủy sản: Các giai đoạn của tôm, cua
- Tác hại:Chết rải rác, hàng loạt
Hội chứng Zoea
- Giai đoạn tôm/thủy sản: Cuối giai đoạn zoea 1
- Tác hại: Chết hàng loạt
Thông tin sản phẩm
Đối tượng sử dụng
Thủy Sản
Tôm Giống
Tôm Quảng Canh
Tôm Thâm Canh
Thành phần
Dịch Vụ
Đánh giá & Nhận xét CHROMagar™ Vibrio
Chưa có đánh giá nào cho sản phẩm này.
Hãy là người đầu tiên đánh giá để giúp người mua khác!
Ưu đãi đặc quyền
- Ưu đãi lớn khi mua số lượng nhiều.
- Tặng mã giảm giá mua hàng qua App.
Thông tin nhanh
Đĩa môi trường CHROMagar Vibrio
Môi trường CHROMagar Vibrio là môi trường sinh màu dùng thể phát hiện nhanh các loài vi khuẩn Vibrio spp. có trong nước ao nuôi và mẫu tôm.
Thành phần
Dịch Vụ
Chính sách Farmext eShop
-
Cam kết 100% chính hãng
Hoàn tiền 200% nếu phát hiện hàng giả
-
Đổi trả dễ dàng
Trong vòng 7 ngày cho mọi lỗi NSX
-
Giao hàng hỏa tốc
Nhận hàng nhanh chóng từ 2-4 ngày

Hỏi đáp & Thảo luận
Chưa có bình luận nào.
Hãy để lại câu hỏi của bạn tại đây!